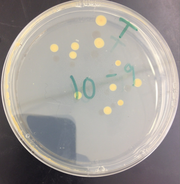
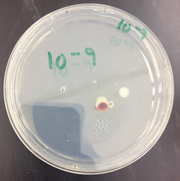
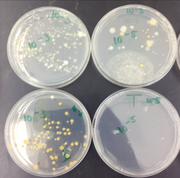

Uploads by Gabriel H Gan
From OpenWetWare
Jump to navigationJump to search
This special page shows all uploaded files.
| Date | Name | Thumbnail | Size | Description |
|---|---|---|---|---|
| 20:48, 28 July 2014 | Ganbacteriablast.png (file) | 32 KB | ||
| 02:27, 17 July 2014 | GanFoodWeb.png (file) |  |
208 KB | |
| 01:43, 17 July 2014 | Gan5Vertebrates.png (file) |  |
146 KB | |
| 20:56, 16 July 2014 | Ganlice.png (file) |  |
49 KB | |
| 20:55, 16 July 2014 | Ganmillipede.png (file) |  |
92 KB | |
| 04:19, 16 July 2014 | Ganbitinglice.png (file) |  |
160 KB | |
| 04:12, 16 July 2014 | Ganarmadillidiidae.png (file) |  |
109 KB | |
| 04:10, 16 July 2014 | Ganspider.png (file) |  |
101 KB | |
| 04:05, 16 July 2014 | Gannematoda.png (file) |  |
221 KB | |
| 03:56, 16 July 2014 | Ganinvertebratetable.png (file) |  |
57 KB | |
| 02:30, 15 July 2014 | Ganbreadmoldimage.png (file) |  |
69 KB | |
| 02:28, 15 July 2014 | Ganbreadmold.png (file) |  |
90 KB | |
| 21:08, 14 July 2014 | Gansamples1to5.png (file) |  |
321 KB | |
| 21:06, 14 July 2014 | Ganleaflittercollectionsite.png (file) |  |
243 KB | |
| 21:06, 14 July 2014 | Ganupdatedsamplemap.JPG (file) |  |
310 KB | |
| 19:09, 14 July 2014 | Ganplant2.png (file) |  |
72 KB | |
| 18:54, 14 July 2014 | Ganplant5.png (file) |  |
62 KB | |
| 18:53, 14 July 2014 | Ganplant4.png (file) |  |
61 KB | |
| 18:51, 14 July 2014 | Ganplant3.png (file) |  |
43 KB | |
| 18:50, 14 July 2014 | Ganplant1.png (file) |  |
45 KB | |
| 18:47, 14 July 2014 | Gansampletable.png (file) | 42 KB | ||
| 20:27, 9 July 2014 | Bacterial Characterization Gan.png (file) |  |
74 KB | |
| 20:26, 9 July 2014 | Screen Shot 2014-07-09 at 4.22.29 PM.png (file) |  |
74 KB | |
| 20:16, 9 July 2014 | 100foldserialdilutiongan.png (file) |  |
29 KB | |
| 02:53, 9 July 2014 | Gan10-9T.png (file) | |
148 KB | |
| 02:53, 9 July 2014 | Gan10-9.png (file) | |
143 KB | |
| 02:52, 9 July 2014 | Gan10-5.png (file) |  |
166 KB | |
| 02:50, 9 July 2014 | Gan petri2.png (file) |  |
169 KB | |
| 02:50, 9 July 2014 | Gan petri1.png (file) | |
225 KB | |
| 02:47, 9 July 2014 | Gan gramstain3.JPG (file) |  |
267 KB | |
| 02:47, 9 July 2014 | Gan gramstain2.JPG (file) |  |
192 KB | |
| 02:46, 9 July 2014 | Gan gramstain1.JPG (file) |  |
208 KB | |
| 16:49, 7 July 2014 | Blepharisma 400x Gan.JPG (file) |  |
102 KB | |
| 00:39, 7 July 2014 | GanOrganismtablewithimages.png (file) |  |
80 KB | |
| 00:28, 7 July 2014 | SerialDilutionGan.png (file) |  |
440 KB | |
| 00:25, 7 July 2014 | Serial dilution diagram.jpg (file) |  |
967 KB | |
| 21:18, 6 July 2014 | Hay Infusion Culture Wet Mount Results Gan.png (file) |  |
39 KB | |
| 19:38, 6 July 2014 | Transect 3 diagram gan.png (file) |  |
131 KB | |
| 19:35, 6 July 2014 | Transect 3 diagram.jpg (file) |  |
260 KB | |
| 19:11, 6 July 2014 | Picsoftranscript3 2.png (file) |  |
470 KB | |
| 19:09, 6 July 2014 | Picsoftranscript3 1.png (file) |  |
444 KB | |
| 18:36, 6 July 2014 | Biotic Abiotic Gan Transect3.png (file) |  |
15 KB | |
| 18:23, 6 July 2014 | Gan Transect3 Map.jpeg (file) |  |
121 KB |